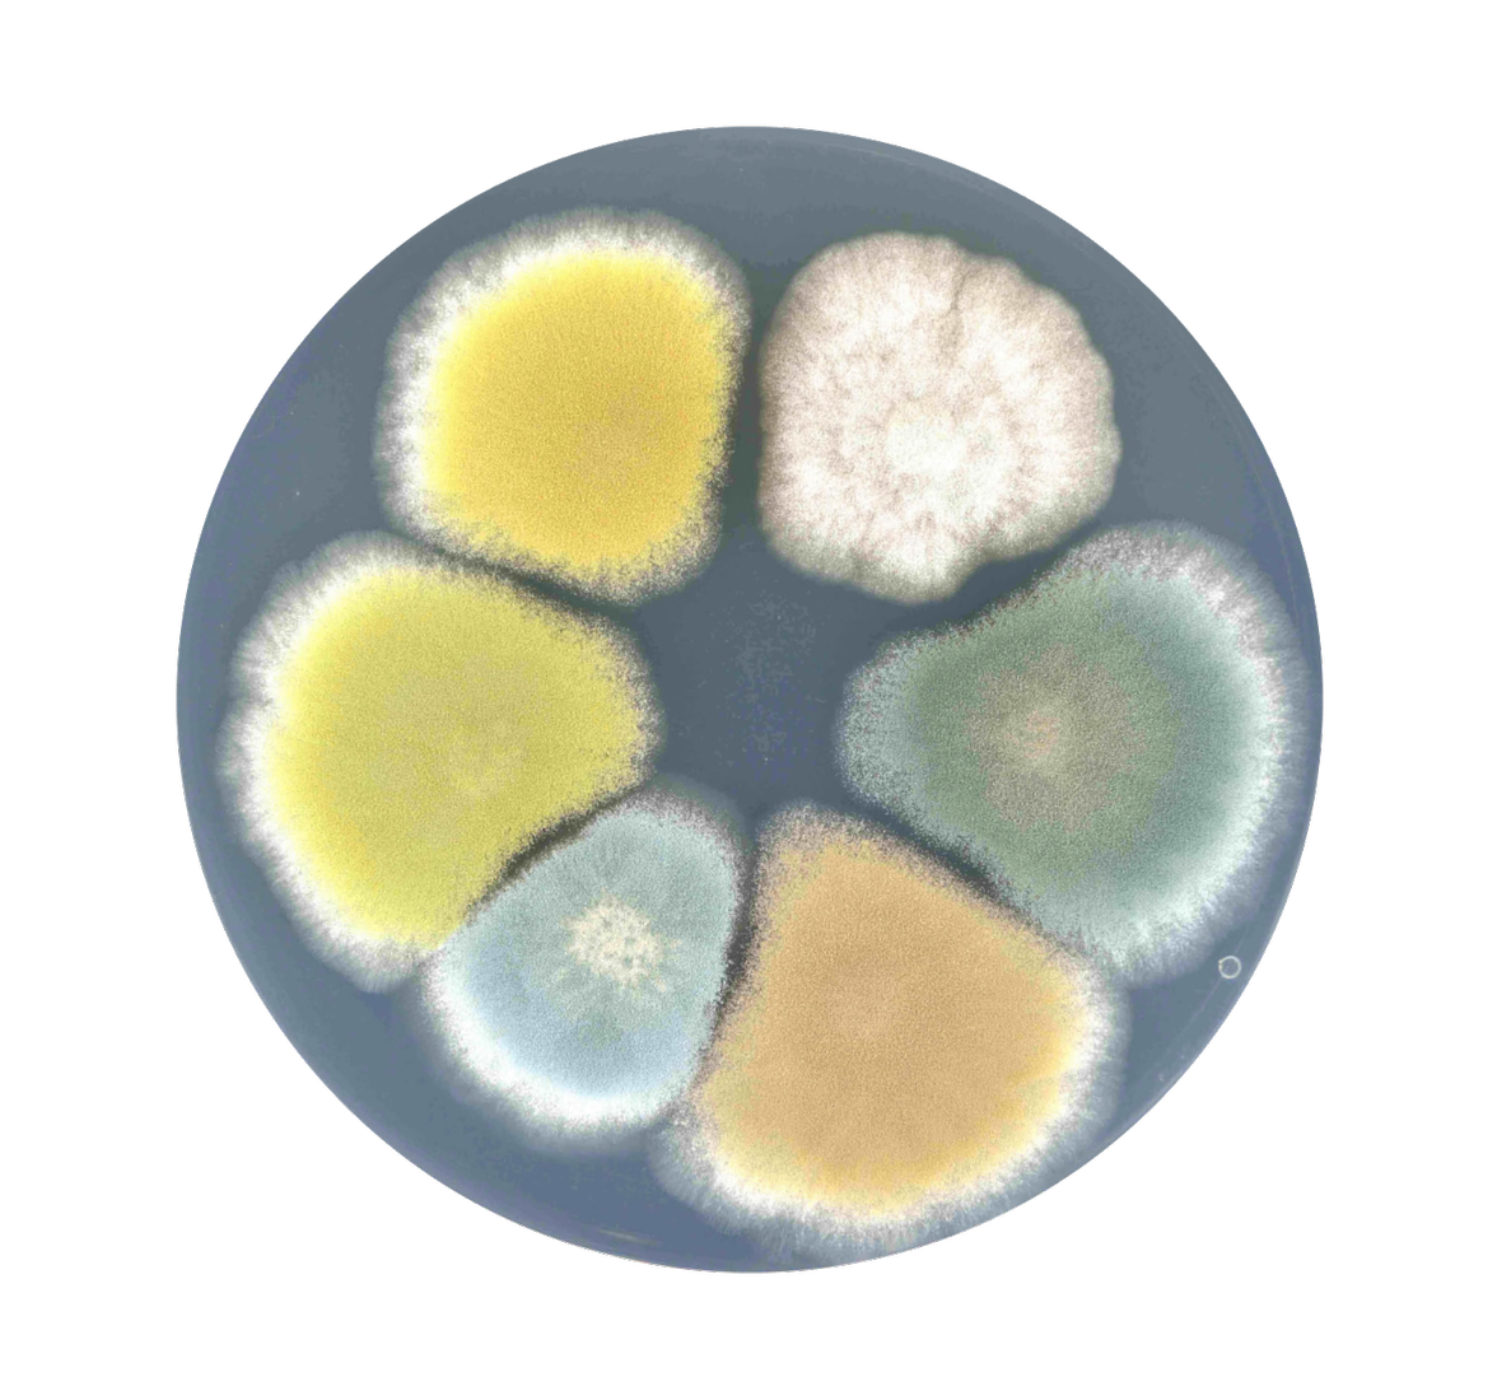

Myconeos is revolutionizing the way we harness fungi for food and beyond. At its core, the company specializes in breeding new fungal strains using proprietary sexual crossing technology, enabling the creation of unique strains for cheese, plant-based foods, and even natural colorants. Behind Myconeos is a team of expert scientists and industry professionals, combining decades of fungal breeding expertise with business acumen. What started as a university spin-off has grown into a pioneering force in cheese culture innovation, shaping a promising future of both dairy and plant-based fermentation.
"We focus on already approved fungi," explains Jacek Obuchowicz, CEO and co-founder of Myconeos. "There are several strains to work with - Penicillium, Fusarium, Aspergillus, and Rhizopus - all with unique properties. Our process involves switching on their sexual cycle under specific conditions to create new, stable progeny with desirable traits."
Beyond stability, Myconeos carefully screens for mycotoxins, ensuring safety before applying the strains to different uses. Whether developing vegan cheese cultures, enhancing dairy fermentation, or exploring natural food colorants, their platform technology allows food producers to innovate and create all kinds of new fermentations.
Flavours and colours in food innovation
Myconeos’ first focus is creating fungal strains that enhance both flavour and colour. Their ‘naturally bred’ range of Mycoforti® strains offer cheese producers the opportunity to achieve unique flavour profiles while reducing production costs, especially in the blue cheese market. These strains provide the ability to create milder or more complex flavours, setting products apart.
Beyond flavour, Myconeos is advancing its strains for fermentation and ingredient production, focusing on natural colours and addressing market needs in dairy, plant-based products, and beyond. "We’re exploring blues and greens from Penicillium roqueforti, as well as reds and yellows," says Jacek. "Consumers buy with their eyes, so having the right colour profile can significantly impact perception. A pale blue cheese might be seen as milder and sweeter, for example."
To bring these innovations to market, Myconeos seeks partnerships with leading companies in the natural flavour and colour industry. "We don’t aim to manufacture ourselves but rather collaborate with industry leaders, leveraging our expertise in fungal breeding while they manage commercialization."

A competitive edge in the market
Despite major players like Novonesis, IFF, Lallemand, and Sacco dominating the dairy culture sector, Myconeos holds a unique advantage - its sexual crossing technology. "Last summer, we were the first to successfully breed Penicillium camemberti, the mould used in Brie and Camembert," Jacek reveals. "French researchers had highlighted the risk of these cheeses dying out due to a lack of new strains, but we’ve developed a solution."
The company’s innovations also extend to vegan cheese. "Traditional strains often struggle with plant-based substrates, risking mycotoxin production. We tailor our strains to these conditions, ensuring better safety, taste, texture and shelf life."
Bioprotection: preventing unwanted contamination
Myconeos has also developed a bioprotection solution to prevent unwanted mould and yeast growth on cheese. Jacek clarifies: "A cheesemaker faced contamination issues, so we identified indigenous yeasts that could outcompete undesirable strains, forming a protective surface coat."

"Last summer, we were the first to successfully breed Penicillium camemberti, the mould used in Brie and Camembert. French researchers had highlighted the risk of these cheeses dying out due to a lack of new strains, but we’ve developed a solution."
Future milestones and market expansion
Having successfully entered the European market in 2024, Myconeos is now focusing on key cheese-producing countries like France, Italy, Denmark, and Germany. "Gorgonzola Dolce is a big focus - consumers want milder, sweeter blue cheeses. We’re trialing new strains for this," Jacek shares.
The company also plans to launch new Penicillium camemberti strains - the first in over 40 years - by the end of this year.
The Planet B.io connection
Recently joining the Planet B.io ecosystem, Myconeos sees significant value in its collaborative environment. "Planet B.io offers the right mix of industry and academia, fostering innovation. It’s not just about the facilities - it’s about the people and the mindset. This ecosystem helps accelerate our work."
Looking ahead, Myconeos is actively exploring the possibility of establishing an office in the Netherlands, further strengthening its presence in Europe.
The future of Myconeos
When asked about the company’s long-term vision, Jacek dreams big. "In five years, I see Myconeos as a leading fungal biotech provider, staying true to natural solutions while potentially exploring CRISPR technologies. Our expertise in breeding new strains will remain central."
Beyond food, Myconeos is eyeing other applications, from mycoprotein production to acting as a scaffold for cellular agriculture. "Fungi also play a crucial role in plant science - improving sustainability, climate resistance, and even environmental remediation. Imagine fungi cleaning up the planet. If we can breed the right strains for that, what a fantastic achievement it would be."
Want to learn more about Myconeos? Check out their website; https://www.myconeos.com/
Are you, like Myconeos, ready to shake things up and start making an impact? We offer flexible solutions to help you establish your presence on our campus. Book a tour today and discover how you can join us!
Are you, like Myconeos, ready to shake things up and start making an impact? We offer flexible solutions to help you establish your presence on our campus. Book a tour today and discover how you can join us!